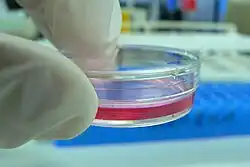

Cosmetic Science/Research Methods
Databases
Databases are a great place to learn more about any particular subject. They compile information from various sources into one location, and provide search tools to aid research. All of the databases listed here are open-access and free to the public. In addition, the databases here are credible sources. Credible means that the databases:
- Use neutral language
- Are supported by scientific or governmental institutions
- Use non-subjective, clearly defined metrics
- Have well-documented references
Chemical Properties
Ingredients Usage and Safety
- Cosmetic Ingredients Review
- Cosmetic Info
- CosIng (maintained by the EU)
Clinical Trials and Scientific Research
- The Journal of the American Medical Association (requires account registration)
- PubMed
- Semantic Scholar
Quality of Scientific Research
...
Governmental Regulations
...
Professionals
In addition to these institutions, individuals working in the industry may share their insights through articles, books, or podcasts. However, the differences between education and job capacity of various professionals may make them unqualified to speak on the same topics. These experts have a lot of useful insights from working in their field. However when experts start speaking outside of their field, they should provide additional references to remain credible.
Cosmetic Chemists
- Typical Educational Attainment: Bachelors in Chemistry, Chemical Engineering, Biology, or Microbiology[1]
- Typical coursework: General Chemistry, Organic chemistry, Inorganic chemistry, Physical chemistry [2]
- Typical Job Roles: formulation, quality control, analytics, process engineering, raw material synthesis, regulation, and sales[1]
- Scope: cosmetic industry practices, formulation, safety concerns
Dermatologists
- Typical Educational Attainment: doctoral degree in medicine (MD) or osteopathic medicine (DO), 1 year internship, and 3 years in dermatology residency.[3]
- Typical Coursework: human anatomy and physiology, pharmacology, biochemistry, microbiology, pathology, genetics, ageing, immunology, nutrition [4]
- Typical Job Roles: surgical procedures, skin diagnosis, injections, hair transplants [3]
- Scope: skin and hair conditions, carcinogenic hazards, surgical procedures, fillers and botox,
Estheticians
- Typical Educational Attainment: state-issued license after completion of around 600 credit hours at a cosmetology school and passing state exam (except in Connecticut) [5]
- Typical Coursework: human anatomy and physiology, massage, skin histology, makeup application, exfoliation, cleansing , sanitation [5]
- Typical Job Roles: massage, body treatment, facial, and nail care [5]
- Scope: massage, exfoliation, product recommendations, makeup looks, spa treatments
References
- ↑ a b [1], Romanowski, P. (n.d.). How to Become a Cosmetic Chemist. Retrieved June 25, 2017, from http://chemistscorner.com/how-to-become-a-cosmetic-chemist/.
- ↑ [2], B.S. Chemistry. (n.d.). Retrieved June 25, 2017, from http://chemistry.berkeley.edu/ugrad/degrees/chem.
- ↑ a b [3]Aad.org. (2017). Why see a dermatologist | American Academy of Dermatology. [online] Available at: https://www.aad.org/public/diseases/why-see-a-dermatologist [Accessed 1 Jul. 2017]
- ↑ [4], Usmle.org. (2017). United States Medical Licensing Examination | Step 1. [online] Available at: http://www.usmle.org/step-1/#content-outlines [Accessed 1 Jul. 2017]
- ↑ a b c [5],Education, Certification & Licensing. (n.d.). Retrieved June 25, 2017, from http://howtobecomeanesthetician.com/